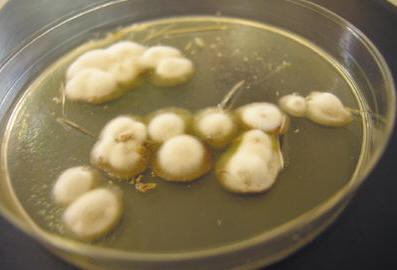

Грибковые инфекции кожи
И. В. Курбатова, кандидат биологических наук
Г. А. Плахотная, кандидат медицинских наук
ИМПиТМ им. Е. И. Марциновского, ММА им. И. М. Сеченова, Москва
Г. А. Плахотная, кандидат медицинских наук
ИМПиТМ им. Е. И. Марциновского, ММА им. И. М. Сеченова, Москва
Грибковые поражения кожи и ее придатков известны с древних времен. Врачи давали заболеваниям кожи, с отличающимися симптомами от других, отдельные обозначения (например, фавус), еще не зная, что причиной их возникновения являются грибы. История науки о дерматофитах началась с открытия в 1839 году Schonlein J. L. возбудителя фавуса Achorion schoenleinii. Schonlein нашел грибной мицелий в высыпаниях на коже больного, которому он ошибочно поставил диагноз «импетиго». В 1841 году Grubi D. установил взаимосвязь между кожными заболеваниями и грибами. Им была описана клиническая картина микроспории и морфологические особенности гриба, вызывающего это заболевание. В результате использования предложенной Sabouraud R. специальной питательной среды для культивирования грибов создались благоприятные условия для микологов-исследователей. Стали проводиться соответствующие клинические и лабораторные исследования, началась эпоха открытия новых видов возбудителей. В области медицинской микологии произошли существенные сдвиги по разным направлениям: были детально изучены и описаны дерматофиты, плесневые, дрожжеподобные грибы, патогенез микотической инфекции, определена природа актиномикоза, усовершенствовалось лечение грибковых заболеваний и т. д. Российские ученые также внесли значительный вклад в развитие медицинской микологии, среди которых наиболее известны П. Н. Кашкин, А. М. Ариевич, Н. Д. Шеклаков, О. К. Хмельницкий, А. Н. Аравийский, З. Г. Степанищева, Н. А. Красильников, Г. О. Сутеев, В. М. Лещенко и многие другие.Грибковые заболевания давно вышли за пределы специальности дерматолога, но по-прежнему дерматологами-микологами проводится большая работа по борьбе с дерматомикозами, занимающими первое место по распространенности во всех странах.
К поверхностным микозам (дерматомикозам) относятся инфекции, которые поражают кожу, ногти и волосы. Основными возбудителями являются дерматофиты, грибы, способные усваивать кератин. К ним относятся грибы родов Microsporum, Trichophyton и Epidermophyton, которые, в зависимости от источника инфекции, делятся на антропофильные, зоофильные и геофильные. Местообитанием зоофильных дерматофитов (Trichophyton mentagrophytes v. gypseum, T. verrucosum, Microsporum canis и др.) являются животные, антропофильных (Trichophyton rubrum, T. mentagrophytes v. interdigitale, Microsporum ferrugineum, Epidermophyton floccosum и др.) — человек, геофильные виды (Microsporum gypseum) обитают в почве. Дерматофиты высококонтагиозны, могут передаваться человеку от человека, животных или из почвы, вызывая заболевание. Основными «распространителями» инфекции являются антропофильные виды.
К поверхностным микозам относятся также кератомикозы: разноцветный лишай и пьедра, при которых поражаются самые поверхностные участки рогового слоя и кутикула волос. Возбудитель разноцветного (отрубевидного) лишая и себорейного дерматита — дрожжеподобный гриб Malassezia furfur — обитает на коже человека и животных и при благоприятных условиях может поражать роговой слой эпидермиса и устья фолликулов. Заболевание в большинстве случаев не контагиозно. Белая и черная пьедры обычно встречаются в странах с жарким и влажным климатом. Заболевания малоконтагиозны. Возбудитель черной пьедры, Piedraia hortae, встречается только на волосах. Trichosporon beigelii широко распространен в окружающей среде и помимо белой пьедры может вызывать также поражения кожи и ногтей.
Помимо истинных дерматофитов, которые инфицируют только кожу и ее придатки, поверхностные микозы могут вызывать и другие грибы, выделяемые из самых различных локализаций при системных микозах. Candida spp. — вторые по частоте выделения при дерматомикозах и онихомикозах после дерматофитов. До 40% случаев онихомикозов кистей вызываютCandida. Отмечены поражения дрожжеподобными грибами волосистой части головы с клинической картиной себорейной экземы. К поверхностным формам кандидоза относят также поражения слизистых полости рта и половых органов.
В случаях с онихомикозами, вызванными плесневыми грибами, до сих пор остается сомнение в способности этих условно-патогенных возбудителей самостоятельно поражать ногти вследствие их слабой протеиназной и кератиназной активности. Известно, что плесневые грибы могут проявляться как вторичная инфекция, проникая в уже пораженные дерматофитами ткани. Однако в результате многолетних исследований доказано, что некоторые плесневые грибы могут внедряться в межклеточное ногтевое пространство с помощью перфоративных органов. Наиболее часто возбудителями плесневых поражений кожи и ногтей являются Scopulariopsis brevicaulis, Pyrenochaeta unguis-hominis, Aspergillus spp., Fusarium spp., Alternaria spp., Cladosporium spp. и др.
Существуют многочисленные варианты классификации грибковых инфекций, в которых в большей или меньшей степени учитывают этиологию, патогенез, клиническую картину и особенности эпидемиологии заболеваний. В отечественной дерматологии чаще всего пользуются классификацией Н. Д. Шеклакова:
Основные клинические особенности грибковых инфекций
Микозы стоп (рис. 1). В основном поражаются межпальцевые складки и подошвы. В межпальцевых складках наблюдаются слабое шелушение с незначительными воспалительными явлениями, умеренная мацерация, трещины, пузырьки. На подошве — утолщение рогового слоя, муковидное шелушение в кожных бороздах, небольшие трещины на слабо гиперемированном фоне. При дисгидротической форме многочисленные пузырьки образуются на коже свода и нижнебоковой поверхности стопы, которые затем сливаются с образованием крупных пузырей. На месте вскрывшихся пузырей остаются эрозии с неровным краем.
Микоз гладкой кожи туловища (рис. 2). При разноцветном лишае пятна коричневатого и белого цвета обычно локализуются на коже груди, спины, шеи и плеч. Шелушащиеся очаги поражения имеют четкие границы и не сопровождаются воспалительными явлениями.
При поражении кожи другими патогенными грибами образуются четко отграниченные, округлые, отечные очаги с приподнятым валиком. Центр очага уплощенный, с незначительным шелушением. Очаги поражения увеличиваются за счет периферического роста.
Микоз паховый. Типичная локализация — внутренняя поверхность бедра, низ живота, ягодицы. Очаги поражения четко очерчены, шелушащиеся, эритематозные, с воспалительным валиком. Со временем общий умеренно эритематозный фон сменяется буроватым.
Микоз волосистой части головы. Чаще всего наблюдается у детей. Заболевание проявляется крупными, округлыми, четко отграниченными, шелушащимися очагами облысения. Воспалительные явления выражены слабо. Волосы измененного цвета в пределах очага обломаны в нескольких миллиметрах над уровнем кожи (при микроспории) или, обламываясь на уровне кожи, оставляют пенек в виде черной точки (при трихофитии). Зоофильные возбудители могут вызывать развитие инфильтративно-нагноительной формы дерматофитии: очаг поражения выступает над окружающей кожей, покрыт гнойно-кровянистыми корками, волосы выпадают.
Онихомикоз. Для различных типов грибкового поражения ногтевых пластинок характерны потеря прозрачности, изменение цвета (белесый, желтоватый), утолщение, подногтевой гиперкератоз, крошение или разрушение вплоть до ногтевого валика.
Микоз кистей. При сквамозной форме поражения ладони заболевание проявляется в мелкопластинчатом муковидном шелушении в кожных бороздах. Могут образовываться трещины, сопровождающиеся болезненными ощущениями и зудом. При дисгидротической форме образуются пузырьки, которые часто группируются и могут сливаться с образованием пузырей.
Микоз лица. Чаще очаги поражения локализуются в области шеи, подбородка и нижней губы. Инфильтративно-нагноительная форма поражения проявляется в образовании крупных синюшно-красных узлов с бугристой поверхностью. Многочисленные пустулы при слиянии образуют абсцессы. Измененные тусклые волосы в очаге поражения извлекаются легко и без боли. Поверхностный вариант напоминает микоз гладкой кожи.
Лабораторная диагностика
Микроскопия клинического материала — быстрый и простой метод предварительной диагностики заболевания. В случаях отсутствия роста возбудителя в культуре положительный результат прямой микроскопии может являться несомненным подтверждением микотической инфекции. В соскобах с кожи и ногтей дерматофиты, как правило, представлены тонким, диаметром 2–4 мкм, прямым и редко ветвящимся мицелием. Часто в препарате можно обнаружить атипичные формы мицелия дерматофитов — цепочки округлых артроспор (рис. 3).
M. furfur при микроскопии чешуек кожи выявляется в виде круглых клеток диаметром 3–8 мкм, собранных в грозди, и коротких изогнутых гифов мицелия характерной «банановидной» формы. В большинстве случаев диагноз разноцветного лишая может быть установлен именно при микроскопии нативного препарата, т. к. посев материала обычно результатов не дает.
Scopulariopsis brevicaulis в ногтевых чешуйках представлен характерными чашковидными спорами с шероховатой оболочкой.
Грибы рода Candida образуют типичные почкующиеся дрожжевые клетки и псевдомицелий (ветвящиеся цепочки из длинных клеток).
Идентификация других возбудителей в нативных препаратах затруднительна.
При поражении волос дерматофитами наблюдают несколько тканевых форм гриба: 1) эндоэктотрикс — споры диаметром 2–3 мкм «мозаично» располагаются внутри и большей частью снаружи волоса, образуя на корне муфту («чехол Адамсона»). Внутри волоса также можно видеть мицелий, который, при легком надавливании на препарат, вылезает из волоса в виде бахромы — «кисти Адамсона». Возбудитель — Microsporum spр.; 2) эндотрикс — споры диаметром 4–6 мкм располагаются внутри волоса продольными цепочками, полностью его заполняя. Возбудитель — Trichophyton spр. Окончательная идентификация грибов проводится при культуральных исследованиях.
Для культуральных исследований патологического материала используется среда Сабуро с хлорамфениколом и гентамицином, а также для селективного выделения дерматофитов — с циклогексимидом (актидионом), для сдерживания роста быстрорастущих сапрофитных грибов.
Роды дерматофитов различают по наличию и морфологии многоклеточных макроконидий и одноклеточных микроконидий.
Характеристика наиболее важных патогенных грибов
Epidermophyton floccosum. Антропофил. Поражает кожу паховых складок, голеней. Колонии растут медленно, серовато-коричневые, лимонно-оливковые, позднее — белые, складчато-бугристые в центре. Поверхность колонии кожистая или бархатисто-мучнистая. При микроскопии: в зрелых культурах встречаются цепочки интеркалярных хламидоспор. Макроконидии 4–5-клеточные, дубинкообразные, гладкие, с закругленными концами. Располагаются пучками по 3–5 штук. Микроконидии отсутствуют.
Microsporum canis (рис. 4). Зооантропофил. Наиболее распространенный возбудитель микроспории на территории России. Колонии быстрорастущие плоские, лучисто-ворсистые. Мицелий серовато-белый, на фоне коричневато-красной или оранжевой обратной стороны общий отенок колонии — лососевый. При микроскопии: образует характерный бамбуковидный мицелий, встречаются гребешки, короткие спирали, интеркалярные хламидоспоры. Макроконидии веретенообразные, остроконечные, шиповатые, многокамерные (4–12-клеточные) с четкой двухконтурной оболочкой. Микроконидии грушевидные, встречаются непостоянно.
M. gypseum. Геофильный возбудитель. Поражает кожу и волосы прежде всего у людей, обрабатывающих почву. Колонии быстрорастущие плоские, мучнистые (порошкообразные), позднее с небольшим бархатистым возвышением в центре. Цвет желтовато-розовый. Обратная сторона желтая. При микроскопии: многочисленные макроконидии (4–6-клеточные) веретенообразной формы, широкие, тупоконечные, гладкие. Микроконидии, если присутствуют, многочисленные, грушевидной или овальной формы.
Trichophyton rubrum (рис. 5). Антропофил. Наиболее распространенный возбудитель дерматомикозов. Поражает ногти стоп, кистей и кожу в любой части тела.
Колонии бархатистые, белые, иногда в начале роста — восковидные, позднее могут приобретать розоватую или пурпурно-красную окраску. Обратная сторона желтого, красного или вишнево-красного цвета. При микроскопии: обильные микроконидии удлиненной, каплевидной или грушевидной формы располагаются по бокам мицелия. Макроконидии 5–6-клеточные, тупоконечные.
T. mentagrophytes var. interdigitale. Антропофил. Поражает ногтевые пластинки и кожу стоп.
Колонии быстрорастущие бархатистые, белые, иногда розоватые. С возрастом у разных штаммов колонии становятся пушистыми или густомучнистыми. Обратная сторона бесцветная или коричневатая. При микроскопии: микроконидии округлые, располагаются по бокам мицелия одиночно и гроздьями. Сигарообразные 3–5-клеточные макроконидии с закругленным концом встречаются редко. В зрелых культурах много завитков и спиралей, образуются узловатые органы и интеркалярные хламидоспоры.
T. mentagrophytes var. gypseum. Зооантропофил. Поражает кожу и волосы. По частоте выделения стоит на втором месте после T. rubrum.
Колонии быстрорастущие плоские, зернисто-порошковатые, белые, кремовые, желтоватые. Обратная сторона коричневато-красная. При микроскопии: микроконидии обильные, округлые, располагаются по бокам мицелия одиночно и виде гроздьев. Макроконидии сигарообразные 3–8-клеточные с закругленными концами.
Лечение
Терапия различных микотических поражений кожи и ногтей проводится противогрибковыми препаратами, которые могут быть системного действия, а также применяться в виде наружных средств. В практической деятельности используется как монотерапия, так и различные комбинации противогрибковых препаратов. В большинстве случаев лечение должно быть комплексным с использованием наружных противогрибковых средств, системных препаратов, симптоматического лечения. Методы и средства топической терапии являются обязательными компонентами лечения различных микотических поражений кожи. Если грибковый процесс находится в начальной стадии и имеются небольшие поражения кожи, то он может быть излечен назначением одних лишь наружных противогрибковых препаратов. При распространенном или глубоком микотическом процессе, а также у больных с поражением волос и ногтей лечение может быть затруднено.
Противогрибковые препараты или антимикотики являются специфическими средствами, используемыми для лечения грибковых поражений кожи, ногтей, волос и др. Они могут обладать фунгицидными и фунгистатическими свойствами. Фунгицидное действие противогрибкового средства приводит к гибели клеток гриба, фунгистатическое — останавливает образование новых клеток грибов. Антимикотики подразделяются условно на 5 групп: полиеновые антибиотики, азольные соединения, аллиламиновые препараты, морфолиновые производные и медикаменты без четкого отношения к какой-либо определенной группе.
При назначении топической терапии важно учитывать характер специфического воздействия противогрибкового средства. Известно, что препараты гризеофульвина активны только в отношении дерматофитов. Наружные средства, содержащие полиеновые антибиотики, — в отношении дрожжевых и плесневых грибов, препараты селена, цинка, бензил бензоата — грибов рода Malassezia и возбудителей эритразмы Corynebacterium minnutissium. Значительно более широким спектром противогрибковой активности, а также противовоспалительными и противозудными свойствами и хорошей переносимостью обладают современные противогрибковые средства азольного, аллиламинового, морфолинового ряда, тиокарбамицины и пиридиновые соединения.
Онихомикоз является наиболее резистентным к терапии заболеванием. В основе успеха лежит индивидуально подобранная лечебная схема. При лечении необходимо учитывать возраст больного, сопутствующие заболевания, количество пораженных ногтей, степень вовлечения в патологический процесс ногтевых пластинок.
В настоящее время врачи-микологи располагают большим арсеналом средств с широким спектром фунгицидного действия, накоплением в терапевтической концентрации в ногтевой пластине и ногтевом ложе. Наибольшее предпочтение отдают препаратам, которые отвечают требованиям по терапевтической эффективности, а также эстетичности и удобству применения.
Лечение онихомикозов подразделяют на местное, системное, комбинированное.
Местное лечение позволяет создавать на поверхности ногтевой пластинки высокие концентрации лекарства. Однако в ногтевое ложе, где располагаются наиболее жизнеспособные грибы, действующие вещества антимикотика не всегда проникают в эффективных концентрациях.
Местные антимикотики: лаки — Лоцерил, Батрафен; кремы — Ламизил, Низорал, Микоспор, Мифунгар, Травоген, Экозакс, Экзодерил, Пимафуцин, спреи — Дактарин, Ламизил и др. Необходимо учесть, что они не предназначены специально для лечения онихомикозов, но ими можно пользоваться при лечении грибковых поражений кожи стоп, межпальцевых промежутков, часто сочетающихся с онихомикозом.
Для лечения ногтей используют также местные антисептики — спиртовые растворы йода, красителей.
Многокомпонентные препараты содержат антимикотик или антисептик в сочетании с противовоспалительным средством. В лечении инфекций кожи, сопровождающих онихомикозы, используются: Тридерм, Травокорт, Микозолон, Пимафукорт, Лоринден С и др.
Азольные, аллиламиновые, морфолиновые соединения, а также препараты смешанной группы активны в отношении большого количества возбудителей. Учитывая то, что достаточно часто микозы стоп вызываются смешанной грибковой флорой, предпочтительнее назначать именно эти препараты, являющиеся антимикотиками широкого спектра действия. Большинство из них повреждает цитоплазматические мембраны клеточных стенок грибов, подавляя синтез их основных компонентов, в частности эргостерола.
В настоящее время врач-миколог располагает высокоэффективными системными антимикотиками: итраконазол (Споронокс, Орунгал), флуконазол (Дифлюкан, Форкан), тербинафин (Ламизил), противогрибковое действие которых отражено в таблице.
Таблица. Спектр активности системных антимикотиков
Одним из важных принципов топической терапии микотических поражений кожи является чередование наружных противогрибковых препаратов, что позволяет избежать резистентности к ним дерматомицетов.
При сквамозно-кератотических формах поражения кожи применяют кератолитические средства в составе коллодийных отслоек или мазей: мазь Аравийского, Ариевича, Андриасяна или 5–10% Салициловую мазь. При кандидозных поражениях используют Нистатиновую, Левориновую, Амфотерициновую мази, Пимафуцин 1–2 раза в день в течение 10–15 дней. В результате лечения разрешаются очаги кандидозного интертриго, межпальцевых кандидозных эрозий, паронихий.
При остро протекающих микозах кожи с выраженным воспалительным компонентом лечение начинают с устранения отека, гиперемии, экссудации, экзематизации, аллергических высыпаний. Назначают примочки и влажно-высыхающие повязки с дезинфицирующими и вяжущими составами: танин, этакридин, борная кислота и др. Затем применяется 2–5% борно-нафталановая паста, 5% паста АСД, а также комбинации противогрибковых и кортикостероидных средств в кремах: Микозолон, Травокорт, Тридерм. При этом быстро устраняются острые воспалительные явления, что позволяет в дальнейшем переходить на лечение фунгицидными средствами. Использовать наружные средства с кортикостероидами рекомендуется 7–8 дней, во избежание активации микотического процесса.
После стихания острых воспалительных явлений или после отслойки рогового слоя при гиперкератозе можно использовать азольные антимикотические препараты: Канестен, Клотримазол, которые применяют от 1 до 3 раз в день, нанося тонким слоем на очаги поражения.
Высокой терапевтической активностью обладают наружные лекарственные формы тербинафина: Ламизил (1% спрей, крем), Ламизил Дермгель (гель). Все формы обладают выраженными антимикотическими и антибактериальными свойствами. Наличие трех лекарственных форм позволяет врачу-микологу применять препарат с наибольшей пользой. Так, спрей Ламизил показан при остропротекающих микозах с гиперемией, отеком, высыпаниями. Орошенные спреем очаги покрываются тонкой пленкой и изолируются от окружающей среды. Спрей Ламизил не вызывает раздражения и приводит к быстрому разрешению участков микоза: исчезает болезненность, зуд, жжение, очаги бледнеют и подсыхают. С помощью спрея Ламизил в течение 5 дней излечиваются очаги эритразмы. В течение 7–10 дней наступает выздоровление у пациентов с различными формами разноцветного лишая. Ламизил Дермгель, также как и спрей, более показан при остропротекающих микозах, так как имеет выраженный охлаждающий эффект и легко наносится на участки поражения. При эритемо-сквамозных и инфильтративных проявлениях микозов кожи показано применение Ламизила в виде крема. Гель и крем этого препарата эффективны также при микроспории, разноцветном лишае, кандидозе крупных складок кожи и околоногтевых валиков. При использовании крема Ламизил в течение одной недели в коже создается такая концентрация препарата, которая сохраняет фунгицидные свойства в течение еще одной недели после его отмены. Этим обстоятельством оправдываются короткие курсы лечения Ламизилом по сравнению с другими местными противогрибковыми средствами.
Терапия микозов волосистой части головы, также как и при лечении гладкой кожи, проводится системными и наружными антимикотиками. На очаги микоза наносят 2–5% настойку йода, вечером смазывают противогрибковой мазью. При явлениях значительного воспаления применяют комбинированные препараты, содержащие помимо антимикотиков кортикостероидные гормоны. При инфильтративно-нагноительном процессе удаляют корки 2–3% Салициловой мазью, используют дезинфицирующие растворы (Фурацилин, перманганат калия). Для повышения эффективности лечения волосы на голове рекомендуется сбривать каждые 10 дней.
К поверхностным микозам (дерматомикозам) относятся инфекции, которые поражают кожу, ногти и волосы. Основными возбудителями являются дерматофиты, грибы, способные усваивать кератин. К ним относятся грибы родов Microsporum, Trichophyton и Epidermophyton, которые, в зависимости от источника инфекции, делятся на антропофильные, зоофильные и геофильные. Местообитанием зоофильных дерматофитов (Trichophyton mentagrophytes v. gypseum, T. verrucosum, Microsporum canis и др.) являются животные, антропофильных (Trichophyton rubrum, T. mentagrophytes v. interdigitale, Microsporum ferrugineum, Epidermophyton floccosum и др.) — человек, геофильные виды (Microsporum gypseum) обитают в почве. Дерматофиты высококонтагиозны, могут передаваться человеку от человека, животных или из почвы, вызывая заболевание. Основными «распространителями» инфекции являются антропофильные виды.
К поверхностным микозам относятся также кератомикозы: разноцветный лишай и пьедра, при которых поражаются самые поверхностные участки рогового слоя и кутикула волос. Возбудитель разноцветного (отрубевидного) лишая и себорейного дерматита — дрожжеподобный гриб Malassezia furfur — обитает на коже человека и животных и при благоприятных условиях может поражать роговой слой эпидермиса и устья фолликулов. Заболевание в большинстве случаев не контагиозно. Белая и черная пьедры обычно встречаются в странах с жарким и влажным климатом. Заболевания малоконтагиозны. Возбудитель черной пьедры, Piedraia hortae, встречается только на волосах. Trichosporon beigelii широко распространен в окружающей среде и помимо белой пьедры может вызывать также поражения кожи и ногтей.
Помимо истинных дерматофитов, которые инфицируют только кожу и ее придатки, поверхностные микозы могут вызывать и другие грибы, выделяемые из самых различных локализаций при системных микозах. Candida spp. — вторые по частоте выделения при дерматомикозах и онихомикозах после дерматофитов. До 40% случаев онихомикозов кистей вызываютCandida. Отмечены поражения дрожжеподобными грибами волосистой части головы с клинической картиной себорейной экземы. К поверхностным формам кандидоза относят также поражения слизистых полости рта и половых органов.
В случаях с онихомикозами, вызванными плесневыми грибами, до сих пор остается сомнение в способности этих условно-патогенных возбудителей самостоятельно поражать ногти вследствие их слабой протеиназной и кератиназной активности. Известно, что плесневые грибы могут проявляться как вторичная инфекция, проникая в уже пораженные дерматофитами ткани. Однако в результате многолетних исследований доказано, что некоторые плесневые грибы могут внедряться в межклеточное ногтевое пространство с помощью перфоративных органов. Наиболее часто возбудителями плесневых поражений кожи и ногтей являются Scopulariopsis brevicaulis, Pyrenochaeta unguis-hominis, Aspergillus spp., Fusarium spp., Alternaria spp., Cladosporium spp. и др.
Существуют многочисленные варианты классификации грибковых инфекций, в которых в большей или меньшей степени учитывают этиологию, патогенез, клиническую картину и особенности эпидемиологии заболеваний. В отечественной дерматологии чаще всего пользуются классификацией Н. Д. Шеклакова:
- Кератомикозы (разноцветный лишай, пьедра, черепитчатый микоз).
- Дерматофитии (эпидермофития, трихофития, микроспория, рубромикоз, фавус и др.).
- Кандидоз (поверхностный кандидоз кожи и слизистых оболочек, висцеральный и др.).
- Глубокие микозы (хромомикоз, споротрихоз и др.).
- Псевдомикозы (эритразма, актиномикоз, нокардиоз и др.).
- Tinea pedis — микоз стоп.
- Tinea corporis — микоз гладкой кожи туловища.
- Tinea cruris — микоз паховый.
- Tinea capitis — микоз волосистой части головы.
- Tinea unguim — онихомикоз.
- Tinea manum — микоз кистей.
- Tinea barbae — микоз лица.
Основные клинические особенности грибковых инфекций
Микозы стоп (рис. 1). В основном поражаются межпальцевые складки и подошвы. В межпальцевых складках наблюдаются слабое шелушение с незначительными воспалительными явлениями, умеренная мацерация, трещины, пузырьки. На подошве — утолщение рогового слоя, муковидное шелушение в кожных бороздах, небольшие трещины на слабо гиперемированном фоне. При дисгидротической форме многочисленные пузырьки образуются на коже свода и нижнебоковой поверхности стопы, которые затем сливаются с образованием крупных пузырей. На месте вскрывшихся пузырей остаются эрозии с неровным краем.Микоз гладкой кожи туловища (рис. 2). При разноцветном лишае пятна коричневатого и белого цвета обычно локализуются на коже груди, спины, шеи и плеч. Шелушащиеся очаги поражения имеют четкие границы и не сопровождаются воспалительными явлениями.
При поражении кожи другими патогенными грибами образуются четко отграниченные, округлые, отечные очаги с приподнятым валиком. Центр очага уплощенный, с незначительным шелушением. Очаги поражения увеличиваются за счет периферического роста.
Микоз паховый. Типичная локализация — внутренняя поверхность бедра, низ живота, ягодицы. Очаги поражения четко очерчены, шелушащиеся, эритематозные, с воспалительным валиком. Со временем общий умеренно эритематозный фон сменяется буроватым.
Микоз волосистой части головы. Чаще всего наблюдается у детей. Заболевание проявляется крупными, округлыми, четко отграниченными, шелушащимися очагами облысения. Воспалительные явления выражены слабо. Волосы измененного цвета в пределах очага обломаны в нескольких миллиметрах над уровнем кожи (при микроспории) или, обламываясь на уровне кожи, оставляют пенек в виде черной точки (при трихофитии). Зоофильные возбудители могут вызывать развитие инфильтративно-нагноительной формы дерматофитии: очаг поражения выступает над окружающей кожей, покрыт гнойно-кровянистыми корками, волосы выпадают.Онихомикоз. Для различных типов грибкового поражения ногтевых пластинок характерны потеря прозрачности, изменение цвета (белесый, желтоватый), утолщение, подногтевой гиперкератоз, крошение или разрушение вплоть до ногтевого валика.
Микоз кистей. При сквамозной форме поражения ладони заболевание проявляется в мелкопластинчатом муковидном шелушении в кожных бороздах. Могут образовываться трещины, сопровождающиеся болезненными ощущениями и зудом. При дисгидротической форме образуются пузырьки, которые часто группируются и могут сливаться с образованием пузырей.
Микоз лица. Чаще очаги поражения локализуются в области шеи, подбородка и нижней губы. Инфильтративно-нагноительная форма поражения проявляется в образовании крупных синюшно-красных узлов с бугристой поверхностью. Многочисленные пустулы при слиянии образуют абсцессы. Измененные тусклые волосы в очаге поражения извлекаются легко и без боли. Поверхностный вариант напоминает микоз гладкой кожи.
Лабораторная диагностика
Микроскопия клинического материала — быстрый и простой метод предварительной диагностики заболевания. В случаях отсутствия роста возбудителя в культуре положительный результат прямой микроскопии может являться несомненным подтверждением микотической инфекции. В соскобах с кожи и ногтей дерматофиты, как правило, представлены тонким, диаметром 2–4 мкм, прямым и редко ветвящимся мицелием. Часто в препарате можно обнаружить атипичные формы мицелия дерматофитов — цепочки округлых артроспор (рис. 3).

Scopulariopsis brevicaulis в ногтевых чешуйках представлен характерными чашковидными спорами с шероховатой оболочкой.
Грибы рода Candida образуют типичные почкующиеся дрожжевые клетки и псевдомицелий (ветвящиеся цепочки из длинных клеток).
Идентификация других возбудителей в нативных препаратах затруднительна.
При поражении волос дерматофитами наблюдают несколько тканевых форм гриба: 1) эндоэктотрикс — споры диаметром 2–3 мкм «мозаично» располагаются внутри и большей частью снаружи волоса, образуя на корне муфту («чехол Адамсона»). Внутри волоса также можно видеть мицелий, который, при легком надавливании на препарат, вылезает из волоса в виде бахромы — «кисти Адамсона». Возбудитель — Microsporum spр.; 2) эндотрикс — споры диаметром 4–6 мкм располагаются внутри волоса продольными цепочками, полностью его заполняя. Возбудитель — Trichophyton spр. Окончательная идентификация грибов проводится при культуральных исследованиях.
Для культуральных исследований патологического материала используется среда Сабуро с хлорамфениколом и гентамицином, а также для селективного выделения дерматофитов — с циклогексимидом (актидионом), для сдерживания роста быстрорастущих сапрофитных грибов.
Роды дерматофитов различают по наличию и морфологии многоклеточных макроконидий и одноклеточных микроконидий.
Характеристика наиболее важных патогенных грибов
Epidermophyton floccosum. Антропофил. Поражает кожу паховых складок, голеней. Колонии растут медленно, серовато-коричневые, лимонно-оливковые, позднее — белые, складчато-бугристые в центре. Поверхность колонии кожистая или бархатисто-мучнистая. При микроскопии: в зрелых культурах встречаются цепочки интеркалярных хламидоспор. Макроконидии 4–5-клеточные, дубинкообразные, гладкие, с закругленными концами. Располагаются пучками по 3–5 штук. Микроконидии отсутствуют.
Microsporum canis (рис. 4). Зооантропофил. Наиболее распространенный возбудитель микроспории на территории России. Колонии быстрорастущие плоские, лучисто-ворсистые. Мицелий серовато-белый, на фоне коричневато-красной или оранжевой обратной стороны общий отенок колонии — лососевый. При микроскопии: образует характерный бамбуковидный мицелий, встречаются гребешки, короткие спирали, интеркалярные хламидоспоры. Макроконидии веретенообразные, остроконечные, шиповатые, многокамерные (4–12-клеточные) с четкой двухконтурной оболочкой. Микроконидии грушевидные, встречаются непостоянно.

Trichophyton rubrum (рис. 5). Антропофил. Наиболее распространенный возбудитель дерматомикозов. Поражает ногти стоп, кистей и кожу в любой части тела.
T. mentagrophytes var. interdigitale. Антропофил. Поражает ногтевые пластинки и кожу стоп.
Колонии быстрорастущие бархатистые, белые, иногда розоватые. С возрастом у разных штаммов колонии становятся пушистыми или густомучнистыми. Обратная сторона бесцветная или коричневатая. При микроскопии: микроконидии округлые, располагаются по бокам мицелия одиночно и гроздьями. Сигарообразные 3–5-клеточные макроконидии с закругленным концом встречаются редко. В зрелых культурах много завитков и спиралей, образуются узловатые органы и интеркалярные хламидоспоры.
T. mentagrophytes var. gypseum. Зооантропофил. Поражает кожу и волосы. По частоте выделения стоит на втором месте после T. rubrum.
Колонии быстрорастущие плоские, зернисто-порошковатые, белые, кремовые, желтоватые. Обратная сторона коричневато-красная. При микроскопии: микроконидии обильные, округлые, располагаются по бокам мицелия одиночно и виде гроздьев. Макроконидии сигарообразные 3–8-клеточные с закругленными концами.
Лечение
Терапия различных микотических поражений кожи и ногтей проводится противогрибковыми препаратами, которые могут быть системного действия, а также применяться в виде наружных средств. В практической деятельности используется как монотерапия, так и различные комбинации противогрибковых препаратов. В большинстве случаев лечение должно быть комплексным с использованием наружных противогрибковых средств, системных препаратов, симптоматического лечения. Методы и средства топической терапии являются обязательными компонентами лечения различных микотических поражений кожи. Если грибковый процесс находится в начальной стадии и имеются небольшие поражения кожи, то он может быть излечен назначением одних лишь наружных противогрибковых препаратов. При распространенном или глубоком микотическом процессе, а также у больных с поражением волос и ногтей лечение может быть затруднено.
Противогрибковые препараты или антимикотики являются специфическими средствами, используемыми для лечения грибковых поражений кожи, ногтей, волос и др. Они могут обладать фунгицидными и фунгистатическими свойствами. Фунгицидное действие противогрибкового средства приводит к гибели клеток гриба, фунгистатическое — останавливает образование новых клеток грибов. Антимикотики подразделяются условно на 5 групп: полиеновые антибиотики, азольные соединения, аллиламиновые препараты, морфолиновые производные и медикаменты без четкого отношения к какой-либо определенной группе.
При назначении топической терапии важно учитывать характер специфического воздействия противогрибкового средства. Известно, что препараты гризеофульвина активны только в отношении дерматофитов. Наружные средства, содержащие полиеновые антибиотики, — в отношении дрожжевых и плесневых грибов, препараты селена, цинка, бензил бензоата — грибов рода Malassezia и возбудителей эритразмы Corynebacterium minnutissium. Значительно более широким спектром противогрибковой активности, а также противовоспалительными и противозудными свойствами и хорошей переносимостью обладают современные противогрибковые средства азольного, аллиламинового, морфолинового ряда, тиокарбамицины и пиридиновые соединения.
Онихомикоз является наиболее резистентным к терапии заболеванием. В основе успеха лежит индивидуально подобранная лечебная схема. При лечении необходимо учитывать возраст больного, сопутствующие заболевания, количество пораженных ногтей, степень вовлечения в патологический процесс ногтевых пластинок.
В настоящее время врачи-микологи располагают большим арсеналом средств с широким спектром фунгицидного действия, накоплением в терапевтической концентрации в ногтевой пластине и ногтевом ложе. Наибольшее предпочтение отдают препаратам, которые отвечают требованиям по терапевтической эффективности, а также эстетичности и удобству применения.
Лечение онихомикозов подразделяют на местное, системное, комбинированное.
Местное лечение позволяет создавать на поверхности ногтевой пластинки высокие концентрации лекарства. Однако в ногтевое ложе, где располагаются наиболее жизнеспособные грибы, действующие вещества антимикотика не всегда проникают в эффективных концентрациях.
Местные антимикотики: лаки — Лоцерил, Батрафен; кремы — Ламизил, Низорал, Микоспор, Мифунгар, Травоген, Экозакс, Экзодерил, Пимафуцин, спреи — Дактарин, Ламизил и др. Необходимо учесть, что они не предназначены специально для лечения онихомикозов, но ими можно пользоваться при лечении грибковых поражений кожи стоп, межпальцевых промежутков, часто сочетающихся с онихомикозом.
Для лечения ногтей используют также местные антисептики — спиртовые растворы йода, красителей.
Многокомпонентные препараты содержат антимикотик или антисептик в сочетании с противовоспалительным средством. В лечении инфекций кожи, сопровождающих онихомикозы, используются: Тридерм, Травокорт, Микозолон, Пимафукорт, Лоринден С и др.
Азольные, аллиламиновые, морфолиновые соединения, а также препараты смешанной группы активны в отношении большого количества возбудителей. Учитывая то, что достаточно часто микозы стоп вызываются смешанной грибковой флорой, предпочтительнее назначать именно эти препараты, являющиеся антимикотиками широкого спектра действия. Большинство из них повреждает цитоплазматические мембраны клеточных стенок грибов, подавляя синтез их основных компонентов, в частности эргостерола.
В настоящее время врач-миколог располагает высокоэффективными системными антимикотиками: итраконазол (Споронокс, Орунгал), флуконазол (Дифлюкан, Форкан), тербинафин (Ламизил), противогрибковое действие которых отражено в таблице.
Таблица. Спектр активности системных антимикотиков

При сквамозно-кератотических формах поражения кожи применяют кератолитические средства в составе коллодийных отслоек или мазей: мазь Аравийского, Ариевича, Андриасяна или 5–10% Салициловую мазь. При кандидозных поражениях используют Нистатиновую, Левориновую, Амфотерициновую мази, Пимафуцин 1–2 раза в день в течение 10–15 дней. В результате лечения разрешаются очаги кандидозного интертриго, межпальцевых кандидозных эрозий, паронихий.
При остро протекающих микозах кожи с выраженным воспалительным компонентом лечение начинают с устранения отека, гиперемии, экссудации, экзематизации, аллергических высыпаний. Назначают примочки и влажно-высыхающие повязки с дезинфицирующими и вяжущими составами: танин, этакридин, борная кислота и др. Затем применяется 2–5% борно-нафталановая паста, 5% паста АСД, а также комбинации противогрибковых и кортикостероидных средств в кремах: Микозолон, Травокорт, Тридерм. При этом быстро устраняются острые воспалительные явления, что позволяет в дальнейшем переходить на лечение фунгицидными средствами. Использовать наружные средства с кортикостероидами рекомендуется 7–8 дней, во избежание активации микотического процесса.
После стихания острых воспалительных явлений или после отслойки рогового слоя при гиперкератозе можно использовать азольные антимикотические препараты: Канестен, Клотримазол, которые применяют от 1 до 3 раз в день, нанося тонким слоем на очаги поражения.
Высокой терапевтической активностью обладают наружные лекарственные формы тербинафина: Ламизил (1% спрей, крем), Ламизил Дермгель (гель). Все формы обладают выраженными антимикотическими и антибактериальными свойствами. Наличие трех лекарственных форм позволяет врачу-микологу применять препарат с наибольшей пользой. Так, спрей Ламизил показан при остропротекающих микозах с гиперемией, отеком, высыпаниями. Орошенные спреем очаги покрываются тонкой пленкой и изолируются от окружающей среды. Спрей Ламизил не вызывает раздражения и приводит к быстрому разрешению участков микоза: исчезает болезненность, зуд, жжение, очаги бледнеют и подсыхают. С помощью спрея Ламизил в течение 5 дней излечиваются очаги эритразмы. В течение 7–10 дней наступает выздоровление у пациентов с различными формами разноцветного лишая. Ламизил Дермгель, также как и спрей, более показан при остропротекающих микозах, так как имеет выраженный охлаждающий эффект и легко наносится на участки поражения. При эритемо-сквамозных и инфильтративных проявлениях микозов кожи показано применение Ламизила в виде крема. Гель и крем этого препарата эффективны также при микроспории, разноцветном лишае, кандидозе крупных складок кожи и околоногтевых валиков. При использовании крема Ламизил в течение одной недели в коже создается такая концентрация препарата, которая сохраняет фунгицидные свойства в течение еще одной недели после его отмены. Этим обстоятельством оправдываются короткие курсы лечения Ламизилом по сравнению с другими местными противогрибковыми средствами.
Терапия микозов волосистой части головы, также как и при лечении гладкой кожи, проводится системными и наружными антимикотиками. На очаги микоза наносят 2–5% настойку йода, вечером смазывают противогрибковой мазью. При явлениях значительного воспаления применяют комбинированные препараты, содержащие помимо антимикотиков кортикостероидные гормоны. При инфильтративно-нагноительном процессе удаляют корки 2–3% Салициловой мазью, используют дезинфицирующие растворы (Фурацилин, перманганат калия). Для повышения эффективности лечения волосы на голове рекомендуется сбривать каждые 10 дней.
Статья опубликована в журнале Лечащий Врач
Комментариев нет:
Отправить комментарий